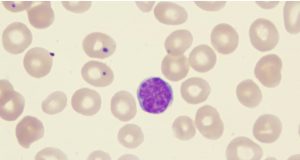
Axicabtagene-ciloleucel-to-treat-Follicular-Lymphoma-admac

Women go through a huge overhaul throughout their lifetimes, and gynecologic health complications might occur […]
The liver, the largest organ of the body, is known to store nutrients, manufacture bile […]
Scientists at University of Birmingham have found that the combination of cholesterol-lowering drug, bezafibrate, and […]
A new clinical trial published in the ‘Journal of Clinical Oncology’ reported that adavosertib can […]
A recent study published in ‘Medicine & Science in Sports & Exercise reported that myokines, […]
Based on the findings of open-label, multi center, single-arm phase 2 trial, the Food and […]
Do you know? Every 1 in 3 women who have battled breast cancer can see […]
Mushrooms often addressed as the ‘elixir of life’ and ‘foods for the Gods’ are the […]
Jackfruit is an exotic anti-cancer fruit which is usually grown in tropical areas of Asian […]
Cancer has been the leading cause of deaths across the globe. Limited efficacy of conventional […]
Cancers are the abnormal growth of cells (mass or tumour) in the body mostly caused […]
The findings of an open-label, single-arm, phase II study published in Onco Targets and Therapy […]
Combined use of ramucirumab and gemcitabine significantly improved overall survival following first-line standard chemotherapy, thus […]
Hovon 143 Study reported that the use of Ixazomib-daratumumab-low-dose-dexamethasone (Ixa-Dara-dex) combination results in higher response […]
Do you know it’s not necessarily the amount of fat, but rather the type of […]
Do you know? Pancreatic cancer is the fourth leading cause of cancer death in western […]
Do you frequently color your hair or dye your hair? Do you test out with […]
Want to increase your chance of surviving prostate cancer? Get yourself tested! Though testing can […]
Your body has a very special system made up of complex network of immune cells […]
A recent study revealed that the use of capecitabine along with temozolomide (CAPTEM) therapy was […]
Do you know that the lymphatic system, a vital part of your body’s immune system, […]
You must have known various risk factors such as smoking, tobacco, environmental carcinogens and even […]
If you have irregular bleeding, unpleasant and foul-smelling vaginal discharge, bleeding between periods, or pain […]
You must have remembered the nucleus, chromosomes and genes from your science class. Nucleus contains […]
June 20, 2021 marked the approval of Rylaze (Asparaginase erwinia chrysanthemi (recombinant)-rywn) by the U.S. […]
On 17 August 2021, dostarlimab received United States Food and Drug Administration (US-FDA) accelerated approval […]
In patients with unresectable or metastatic biliary tract cancer, nab-paclitaxel plus gemcitabine-cisplatin (Gem/Cis/nab-P) showed favorable […]
Having a serious physical illness such as cancer and various complications associated with it such […]
Craving for chocolate? Try small amounts of high-quality dark chocolate. This common favourite delightful treat […]
Beware! If you smoke regularly, then you are at an elevated risk of getting lung […]
Cancer is a life threatening disorder and comes with a lot of distress in patients. […]
You must have noticed any scar or mole on your skin. But, do you know, […]
Battling breast cancer in women begins with finding it. Early identification of tumors in the […]
Cancer treatment is a long journey and often takes a toll on your body. It […]
Being diagnosed with cancer is bad news, but tackling these hard core disorders becomes even […]
Colonoscopy is a screening technique that is used significantly in the diagnosis and management of […]
Bone is the supporting framework for your body and performs several vital functions such as […]
In a prospective, randomized controlled study carried out by Huang Jing et al., the neoadjuvant […]
Every year, millions of cancer patients could be saved from premature death and suffering if […]
The combination of magrolimab and trastuzumab can be a promising therapeutic approach towards HER2+ breast […]
Blood is composed of red blood cells, white blood cells, plasma and platelets. It is […]
Oral cancer is known to be the 15th most common type of cancer around the […]
Tiredness, lack of energy and exhaustion, fatigue is a condition that you can feel either […]
Food and Drug Administration (FDA) has recently approved brigatinib against anaplastic lymphoma kinase (ALK)-positive metastatic […]
In the past few years, the survival rates of cancer patients are rising because of […]
FDA has recently granted an approval to Cemiplimab-rwlc for management of patients with locally advanced […]
With 15% of cases each year, breast cancer is quite uncommon among younger women, especially […]
Patients with neuroendocrine tumours often experience an alteration in nutrition and metabolism due to excessive […]
Cognitive impairment ‘Chemo Brain’, might be new to you, but it is not new in […]
“KRAS mutations have long been considered resistant to drug therapy, representing a true unmet need […]
Cancer is considered to be the worst enemy of humanity. It impairs patients’ quality of […]
Occult primary cancer is a rare metastatic cancer type whose origin remains unidentified following the […]
Identifying rare tumors is a major issue as it might be associated with delay in […]
In the effort to defeat skin cancer, knowledge is the key weapon in your armoury. […]
Eye cancer is a life-threatening ocular disease but is also fairly unknown. It is rare […]
COVID-19 is a global crisis and has continued to spread around the globe at a […]
A recent study published in “The Lancet Oncology” reported that compared with carboplatin-based doublet (standard […]
When you heard of the tumour, you may likely think of cancer. Both the terms […]
You must have heard of chemotherapy as a potential drug treatment for various types of […]
Ovarian cancer, one of the most deadly gynecologic cancers, is often overlooked and under-diagnosed. In […]
On 5th May 2021, the United States Food and Drug Administration (US-FDA) granted its approval […]
In the journey of colon cancer, a healthy diet is crucial at each step. Eating […]
A study published in “The Lancet Haematology” depicted that lenalidomide after autologous haematopoetic stem-cell transplantation […]
Prostate cancer (also called prostate carcinoma) develops in the prostate gland, located below the urinary […]
Although there is plenty of awareness of breast cancer, it is pretty mind-boggling that some […]
The preliminary data of a study published in “BJU International” indicated that the addition of […]
In patients suffering from metastatic triple-negative breast cancer, the progression-free and overall survival were found […]
For cancer patients, it is common to have hypertension (high blood pressure). The significance of […]
When we talk about blood cancer, it means the cancer of blood, bone marrow, and […]
Esophageal cancer, a devastating ailment affecting an individual’s esophagus, is on the rise! Worldwide, cancer […]
Cancer, a life-threatening malignancy, is the leading cause of death worldwide, accounting for approximately 10 […]
A study published in “Cancer Treatment Reviews” demonstrated that in castration-resistant metastatic prostate cancer (mCRPC) […]
When it comes to oral health, most of the people are focused majorly on reducing […]
Brain cancer or brain tumor is a rare and deadly malignancy with a low survival […]
Colorectal cancer or colorectal tumor is the third most common type of cancer and the […]
On 7th April 2021, sacituzumab govitecan received US-FDA approval to treat individuals having unresectable locally […]
Following a healthy lifestyle is essential as it can help you to improve your longevity […]
On 5 March 2021, axicabtagene ciloleucel received accelerated approval by the USFDA to treat adults […]
As per the notification on 10 March 2021, tivozanib received Food and Drug Administration (FDA) […]
Lung cancer also known as lung tumor is the second most common cancer and the […]